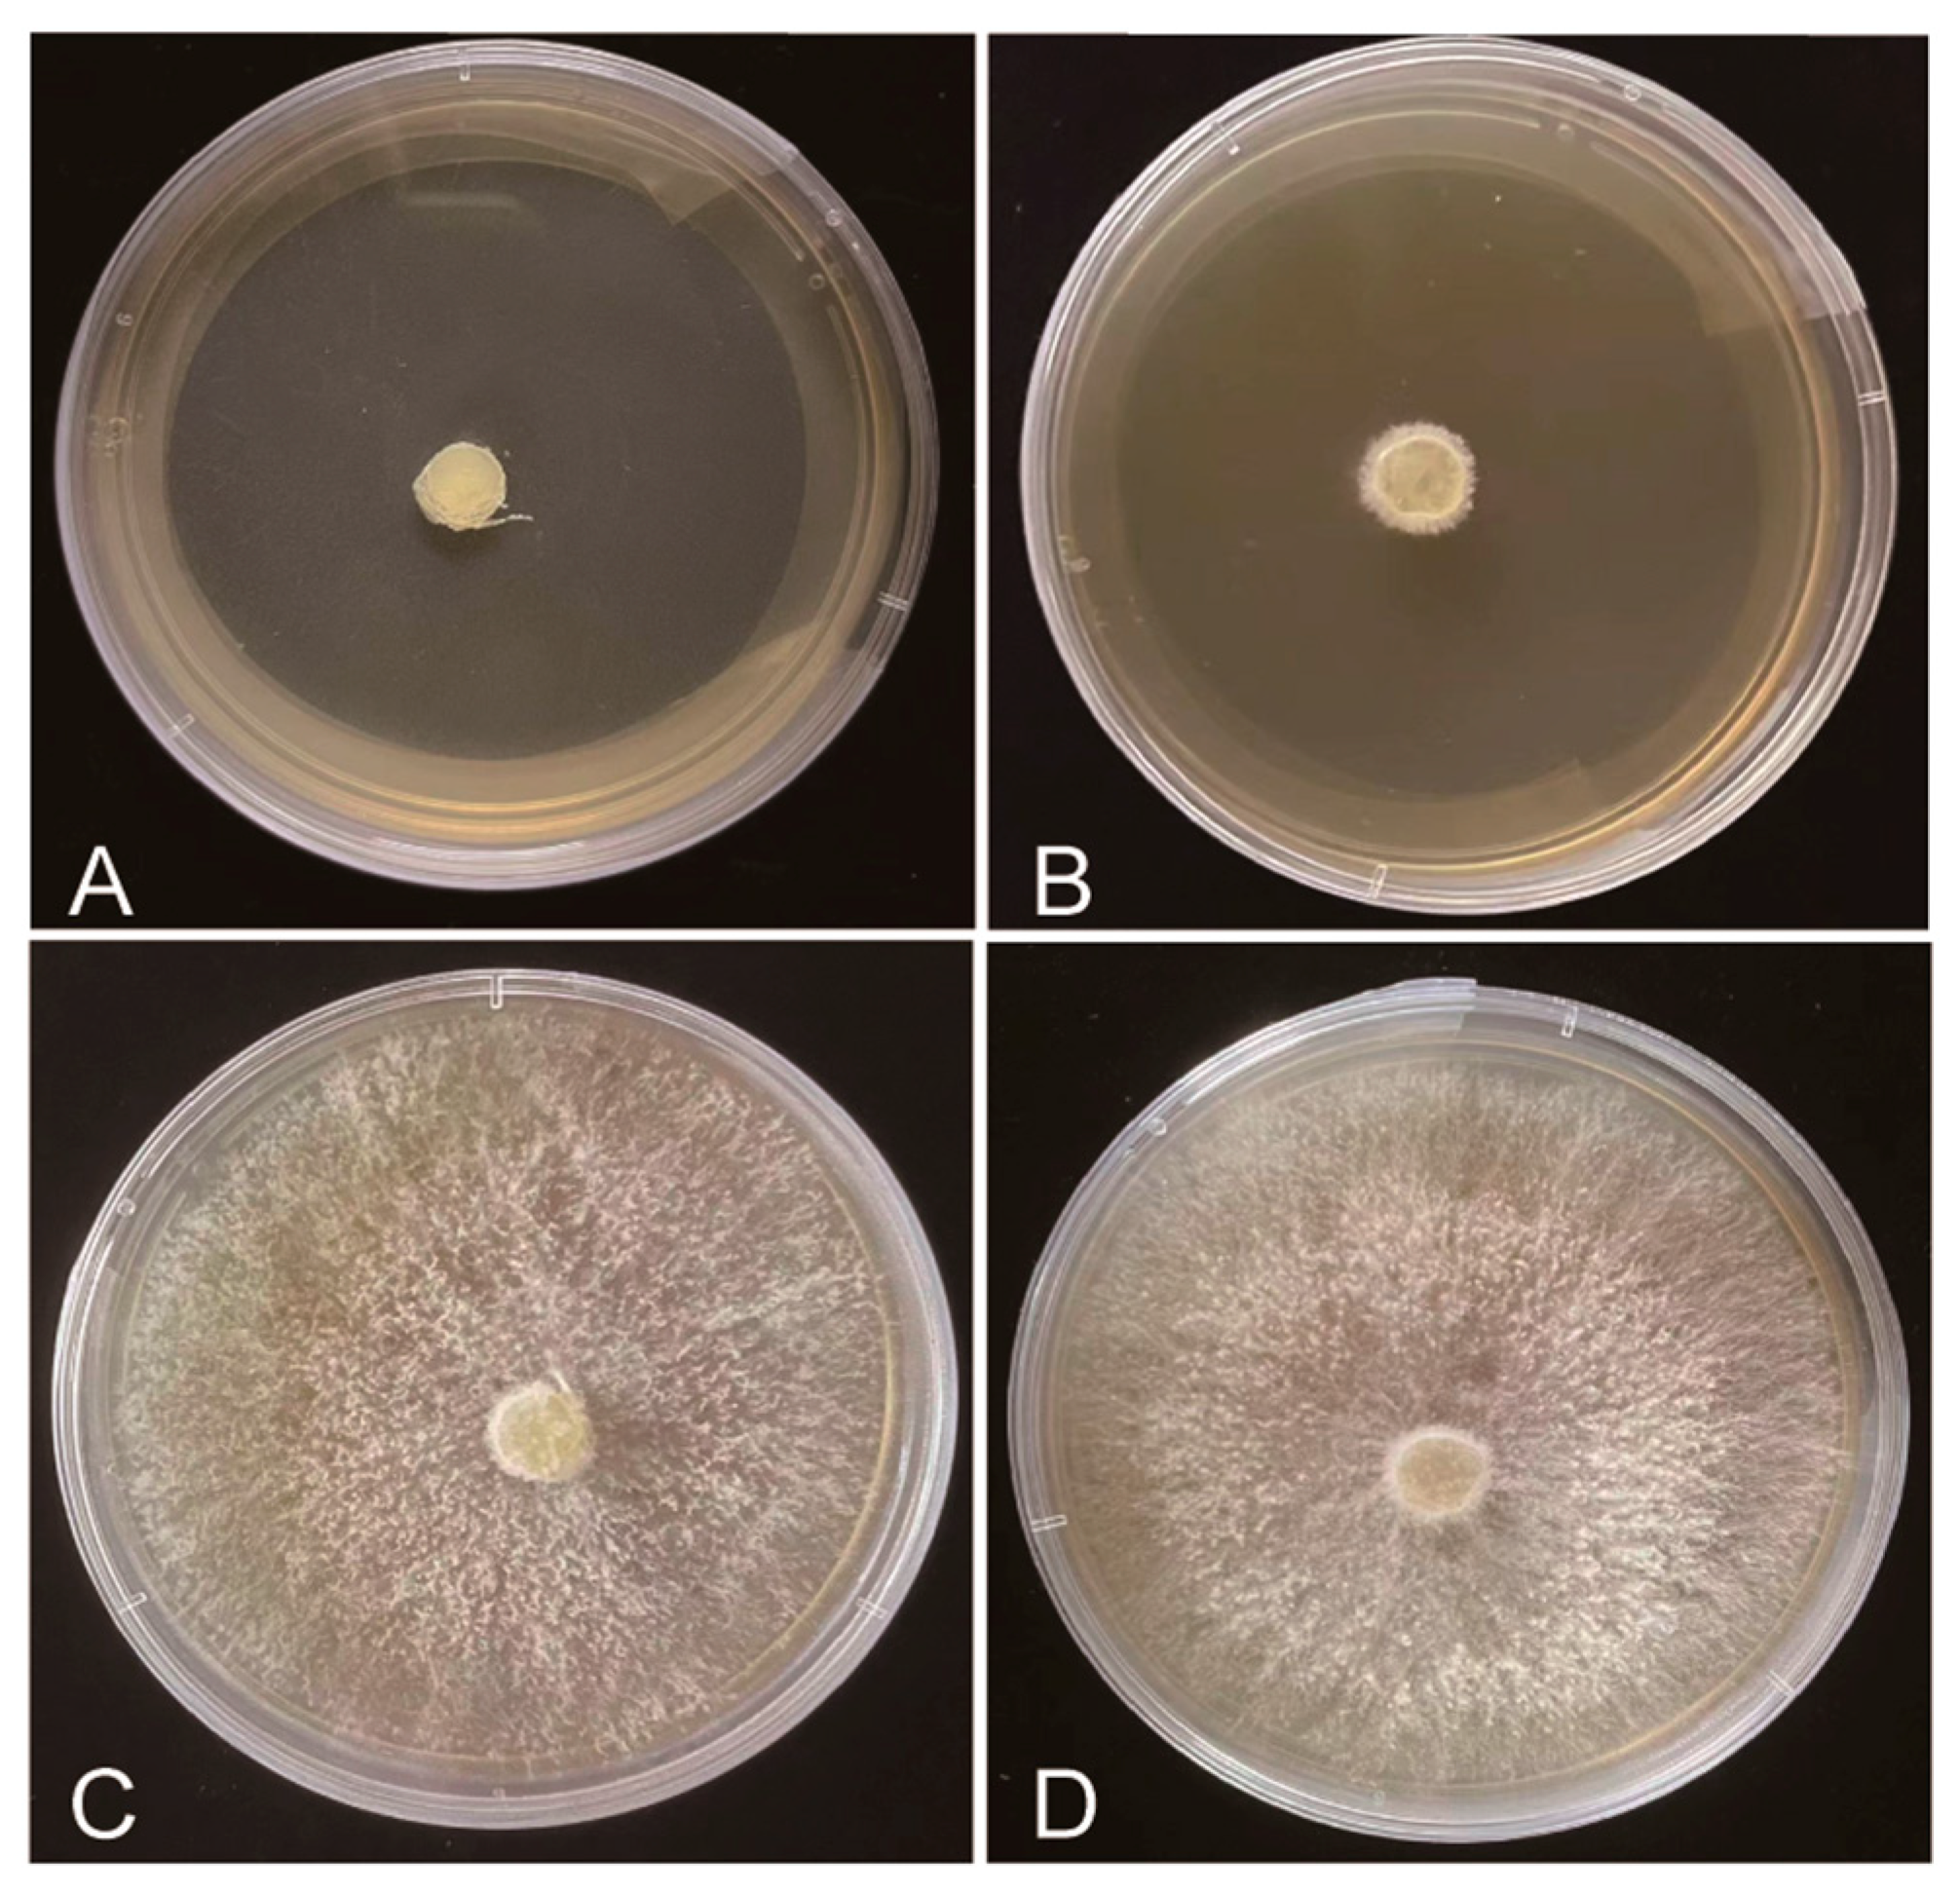
Plants 12 03149 g003

Screening for Fungicide Efficacy in Controlling Blackleg Disease in Wasabi (Eutrema japonicum)
Abstract
:1. Introduction
2. Results
2.1. Isolation and Identification of the Pathogen of Blackleg Disease
2.2. Symptom Development of Blackleg Disease in Wasabi
2.3. Evaluation of Fungicide Efficacy via Fungistasis Testing
2.4. Evaluation of Fungicide Efficacy on Live Seedlings
2.5. Sequence Analysis of the CYP51 and CYTB Genes
3. Discussion
4. Materials and Methods
4.1. Pathogen Isolation of Blackleg Disease
4.2. Pathogen Identification
4.3. Pathogenicity Determination
4.4. The Incidence of Blackleg Disease in Wasabi
4.5. Evaluation of Fungicide Efficacy via Fungistasis Testing
4.6. Evaluation of Fungicide Efficacy on Live Seedlings
4.7. Sequence Amplification of CYP51 and CYTB from P. wasabiae
Author Contributions
Funding
Data Availability Statement
Conflicts of Interest
References
- Bell, L.; Oloyede, O.O.; Lignou, S.; Wagastaff, C.; Methven, L. Taste and flavor perceptions of glucosinolates, isothiocyanates, and related compounds. Mol. Nutr. Food Res. 2018, 62, 1700990. [Google Scholar] [CrossRef]
- Kurilich, A.C.; Tsau, G.J.; Brown, A.; Howard, L.; Klein, B.P.; Jeffery, E.H.; Kushad, M.; Wallig, M.A.; Juvik, J.A. Carotene, tocopherol, and ascorbate contents in subspecies of Brassica oleracea. J. Agr. Food Chem. 1999, 47, 1576–1581. [Google Scholar] [CrossRef]
- Lu, Z.J.; Dockery, C.R.; Crosby, M.; Chavarria, K.; Patterson, B.; Giedd, M. Antibacterial activities of wasabi against escherichia coli O157:H7 and staphylococcus aureus. Front. Microbiol. 2016, 7, 1403. [Google Scholar]
- Thomaz, F.S.; Altemani, F.; Panchal, S.K.; Worrall, S.; Nitert, M.D. The influence of wasabi on the gut microbiota of high-carbohydrate, high-fat diet-induced hypertensive Wistar rats. J. Hum. Hypertens. 2021, 35, 170–180. [Google Scholar] [CrossRef] [PubMed]
- Lee, Y.; Yang, J.; Bae, M.; Yoo, W.; Ye, S.; Xue, C.; Li, C.G. Anti-oxidant and anti-hypercholesterolemic activities of Wasabia japonica. Evid. Based Complement. Altern. Med. 2008, 7, 459–464. [Google Scholar] [CrossRef] [PubMed]
- Wang, Y.H.; Wang, Z.B.; Xu, R.H.; Zhang, Y.; Yang, Y. Study on the removal of nitrite from food by horseradish leaching solution. China Condi. 2019, 44, 31–34. [Google Scholar]
- Liu, Y.Q.; Liu, P.; Jiang, Z.J.; Chen, Z.P.; Wang, Z.Z.; Li, Y.F. Research progress on bioactive components and health care function of horseradish. Food Nutr. China 2017, 23, 59–62. [Google Scholar]
- Wu, M.G.; Quan, B.W.; Pu, F.Z.; Quan, Y.H.; Cai, C.P. Study on bio-ecological characteristics of horseradish. J. Agric. Sci. Yanbian Univ. 2000, 3, 211–216. [Google Scholar]
- Cai, G. Collection, treatment and storage of Wasabi seeds. Seed 2002, 6, 106. [Google Scholar]
- Iijima, T. Cultivation techniques of horseradish. Breed. Agric. 1950, 5, 12–14. [Google Scholar]
- Tanaka, I.; Ito, Y.; Shinozuka, M.; Shimazu, T. Studies on indoor artificial light cultivation of horseradish: Effect of temperature and solution temperature on growth. Plant Environ. Eng. 2009, 21, 175–178. [Google Scholar]
- He, W.X.; Wu, Z.P.; Ning, H.; Zhang, F.L.; Fan, J.A.; He, T.J. Investigation on diseases and pests of horseradish in Sichuan. South west China J. Agric. Sci. 2005, 1, 63–65. [Google Scholar]
- Zhang, F.L.; Ning, H.; Zhang, M.; He, W.X.; Li, G.; He, T.J. Biological characters of Phoma wasabiae causing black rot of wasabi. Plant Prot. 2004, 4, 45–48. [Google Scholar]
- Reddy, P.V.; Paetl, R.; White, J.F. Phylogenetic and developmental evidence supporting reclassification of cruciferous pathogens Phoma lingam and Phoma wasabiae in Plenodomus. Can. J. Bot. 1998, 76, 1916–1922. [Google Scholar]
- Tang, X.M.; Lin, M.S.; Wei, M.Y.; Zhang, S.X.; Ren, X.S.; Zhang, C.Y. Investigation on the occurrence and harmfulness of black heart disease and white rust disease of mountain anemone in the field. Plant Quar. 2002, 5, 292–295. [Google Scholar]
- Soga, O. Studies on the Blackish substance found in wasabi afflicted with black leg disease (Eutrema Wasabi Marim). Nat. Sci. 1966, 16, 90–97. [Google Scholar]
- Quan, W.R.; Wu, M.G.; Nan, C.X.; Xue, G.X. Black entry of horseradish and its control. J. Agric. Sci. Yanbian Univ. 2008, 2, 129–132. [Google Scholar]
- Xi Dao, Z.Y. Countermeasures against insect pest in Wasabi cultivation. Spec. Seed 2015, 20, 59–63. [Google Scholar]
- Hoffmeister, M.; Zito, R.; Bohm, J.; Stammler, G. Mutations in Cyp51 of Venturia inaequalis and their effects on DMI sensitivity. J. Plant Dis. Prot. 2021, 128, 1467–1478. [Google Scholar] [CrossRef]
- Gisi, U.; Sierotzki, H.; Cook, A.; Mccaffery, A. Mechanisms influencing the evolution of resistance to Qo inhibitor fungicides. Pest Manag. Sci. 2002, 58, 859–867. [Google Scholar] [CrossRef]
- Garnault, M.; Duplaix, C.; Leroux, P.; Couleaud, G.; David, O.; Walker, A.S.; Carpentier, F. Large-scale study validates that regional fungicide applications are major determinants of resistance evolution in the wheat pathogen Zymoseptoria tritici in France. New Phytol. 2021, 229, 3508–3521. [Google Scholar] [CrossRef] [PubMed]
- Fernandez, O.D.; Tores, J.A.; De, V.A.; Perez, G.A. Mechanisms of resistance to QoI fungicides in phytopathogenic fungi. Int. Microbiol. 2008, 11, 1–9. [Google Scholar]
- Zhou, Z.Y.; Li, C.C.; Gao, T.C.; Tan, G.J. Research progress of triazole fungicides. J. Anhui Agric. Sci. 2008, 36, 11842–11844. [Google Scholar]
- Su, P.; Zhou, Z.Q.; Hou, H.; Wang, L.; Zhu, J.L. Examination of the sensitivity of Botryosphaeria berengeriana f. sp. piricola to tebuconazole. J. Fruit Sci. 2010, 27, 69–76. [Google Scholar]
- Xue, Z.M.; Zhang, Y.J.; Ma, X.B.; Su, C.; Ren, J.L. Field efficacy of a new fungicide tebuconazole against Mulberry sclerotinia. North Sericu. 2017, 38, 20–23. [Google Scholar]
- Cao, H.C.; Li, X.H.; Wang, X.K.; Bai, H.X.; Mu, W.; Liu, F. Control efficacy of pyraclostrobin and triazole fungicides against tomato crown and root rot. Sci. Agric. Sin. 2018, 51, 4065–4075. [Google Scholar]
- Villani, S.M.; Hulvey, J.; Hily, J.M.; Cox, K.D. Overexpression of the CYP51A1 gene and repeated elements are associated with differential sensitivity to DMI fungicides in Venturia inaequalis. Phytopathology 2016, 106, 562–571. [Google Scholar] [CrossRef]
- Mair, W.; Lopez, R.F.; Stammler, G.; Clark, W.; Burnett, F.; Hollomon, D.; Ishii, H.; Thind, T.S.; Brown, J.K.; Fraaije, B. Proposal for a unified nomenclature for target-site mutations associated with resistance to fungicides. Pest Manag. Sci. 2016, 72, 1449–1459. [Google Scholar] [CrossRef]
- Sanglard, D.; Ischer, F.; Koymans, L.; Bille, J. Amino acid substitutions in the cytochrome P-450 lanosterol 14alpha-demethylase (CYP51A1) from azole-resistant Candida albicans clinical isolates contribute to resistance to azole antifungal agents. Antimicrob. Agents Chemother. 1998, 42, 241–253. [Google Scholar] [CrossRef]
- Chai, Q.Y.; Xu, J.Q.; Guo, Y.W.; Hou, Y.; Hou, X.G.; Liu, S.M. Inhibitory activity of three types of fungicides on Cladosporium paeoniae and their control efficacy against paeony leaf mold. Eur. J. Plant Pathol. 2022, 163, 707–717. [Google Scholar] [CrossRef]
- Sierotzki, H.; Frey, R.; Wullschlegar, J.; Palermo, S.; Karlin, S.; Godwin, J.; Gisi, U. Cytochrome b gene sequence and structure of Pyrenophora teres and P. tritici-repentis and implications for QoI resistance. Pest Manag. Sci. 2007, 63, 225–233. [Google Scholar] [CrossRef] [PubMed]
- Zhang, Y.J. Study on Isolation and Identification of Endophytic Fungi from Eutrema wasabi maxim and Its Prevention Activity against Phoma wasabiae Yokogi. Master’s Degree, Sichuan Agricultural University, Chengdu, China, 2015. [Google Scholar]
- Li, Y.J.; Pu, M.Y.; Cui, Y.S.; Chen, X.; Wang, L.Q.; Wu, H.Z.; Yang, Y.Y.; Wang, C. Research on the isolation and identification of black spot disease of Rosa chinensis in Kunming, China. Sci. Rep. 2023, 13, 8299. [Google Scholar] [CrossRef] [PubMed]

| Fungicides | Diameter of Colony (cm) on the 7th Day | Inhibition Index | Diameter of Colony (cm) on the 14th Day | Inhibition Index | ||||
|---|---|---|---|---|---|---|---|---|
| R 1 | R 2 | R 3 | R 1 | R 2 | R3 | |||
| CK | 7.60 | 7.55 | 7.58 | -- | 8.10 | 8.20 | 8.10 | -- |
| Dimethomorph | 7.30 | 5.20 | 7.10 | 13.80 ± 8.69 e | 8.10 | 8.15 | 8.10 | 0.20 ± 0.20 g |
| Azoxystrobin | 5.50 | 5.60 | 4.50 | 31.36 ± 4.66 d | 8.00 | 7.90 | 8.05 | 1.84 ± 0.93 g |
| Valomyl | 2.55 | 2.90 | 2.50 | 65.02 ± 1.72 c | 3.70 | 3.75 | 3.60 | 54.71 ± 0.42 b |
| Chlorothalonil | 3.60 | 3.90 | 3.40 | 52.04 ± 1.99 c | 6.20 | 6.35 | 6.05 | 23.78 ± 0.81 d |
| Famoxadone | 3.80 | 3.10 | 3.40 | 54.70 ± 2.59 c | 6.50 | 6.60 | 6.50 | 19.67 ± 0.08 e |
| Prochloraz | 5.50 | 5.10 | 5.20 | 30.49 ± 1.46 d | 8.10 | 8.10 | 8.10 | 0.41 ± 0.41 g |
| Topsin-m | 4.20 | 3.90 | 4.20 | 38.86 ± 7.68 d | 7.00 | 6.85 | 7.10 | 14.13 ± 1.22 f |
| Pyraclostrobin | 0.00 | 0.00 | 0.00 | 100.00 ± 0.00 a | 0.00 | 0.00 | 0.00 | 100.00 ± 0.00 a |
| Tebuconazole | 0.00 | 0.00 | 0.00 | 100.00 ± 0.00 a | 0.00 | 0.00 | 0.00 | 100.00 ± 0.00 a |
| Difenoconazole | 1.50 | 1.50 | 2.00 | 78.00 ± 2.20 b | 4.80 | 4.75 | 4.90 | 40.77 ± 0.74 c |
| Fungicide | Spraying before Inoculation | Spraying after Inoculation | ||
|---|---|---|---|---|
| Disease Index | Control Efficacy | Disease Index | Control Efficacy | |
| CK | 65.29 ± 0.42 a | —— | 65.29 ± 0.42 a | —— |
| Dimethomorph | 57.33 ± 1.33 a | 12.15 ± 2.63 b | 57.57 ± 1.30 ab | 11.83 ± 1.97 c |
| Difenoconazole | 58.84 ± 2.36 a | 9.85 ± 4.07 b | 34.89 ± 0.89 d | 46.57 ± 1.22 a |
| Tebuconazole | 34.29 ± 3.30 b | 47.48 ± 5.03 a | 35.24 ± 0.95 d | 46.03 ± 1.31 a |
| Valomyl | 40.67 ± 2.40 b | 37.70 ± 3.80 a | 47.56 ± 5.78 bc | 27.27 ± 8.43 bc |
| Pyraclostrobin | 39.78 ± 3.89 b | 39.03 ± 6.17 a | 40.81 ± 5.50 cd | 37.45 ± 8.53 ab |
| Fungicide | Root Irrigation before Inoculation | Root Irrigation after Inoculation | ||
|---|---|---|---|---|
| Disease Index | Control Efficacy | Disease Index | Control Efficacy | |
| CK | 66.67 ± 1.28 a | —— | 66.67 ± 1.28 a | —— |
| Dimethomorph | 60.00 ± 2.31 b | 10.00 ± 3.00 d | 59.52 ± 2.08 a | 10.72 ± 2.51 b |
| Difenoconazole | 53.81 ± 1.72 b | 19.25 ± 2.64 c | 45.43 ± 3.31 b | 31.98 ± 3.73 a |
| Tebuconazole | 39.52 ± 2.90 d | 40.74 ± 3.97 a | 46.67 ± 0.95 b | 29.95 ± 1.93 a |
| Valomyl | 46.67 ± 1.33 c | 30.02 ± 1.09 b | 48.00 ± 2.31 b | 27.81 ± 4.86 a |
| Pyraclostrobin | 42.29 ± 2.62 cd | 36.67 ± 2.85 ab | 48.57 ± 3.30 b | 27.19 ± 4.46 a |
| Fungicide Name | Concentration (μg·mL−1) | Spraying after Inoculation | |
|---|---|---|---|
| Disease Index | Control Efficacy | ||
| CK | —— | 65.29 ± 0.42 a | —— |
| Tebuconazole | 600 | 35.24 ± 0.95 b | 46.03 ± 1.31 b |
| 1200 | 26.00 ± 3.06 c | 60.15 ± 4.75 a | |
| 1800 | 30.00 ± 0.00 bc | 54.05 ± 0.30 ab | |
| 2400 | 23.33 ± 3.33 c | 64.19 ± 5.37 a | |
| Pyraclostrobin | 3000 | 34.89 ± 0.89 b | 46.57 ± 1.22 ab |
| 6000 | 27.78 ± 2.22 bc | 57.43 ± 3.54 ab | |
| 9000 | 26.67 ± 3.85 c | 59.15 ± 5.86 ab | |
| 12,000 | 26.67 ± 3.33 c | 59.12 ± 5.23 ab | |
| Fungicide | Effective Content | Recommended Concentration (g·mL−1) | Fungicide Type | Protectant/Systemic |
|---|---|---|---|---|
| Dimethomorph | 10.00% | 5000 | Morpholines | Systemic |
| Azoxystrobin | 45.00% | 2000 | Methoxy acrylate | Systemic |
| Valomyl | 66.80% | 3000 | Amino acid derivative | Systemic |
| Famoxadone | 25.00% | 3000 | Oxazolone | Protectant |
| Hymexazol | 45.00% | 1000 | Imidazole | Systemic |
| Topsin-methyl | 50.00% | 2000 | Benzimidazole | Systemic |
| Difenoconazole | 10.00% | 3000 | Triazoles | Systemic |
| Chlorothalonil | 38.00% | 4000 | Aromatics | Protectant |
| Tebuconazole | 30.00% | 600 | Triazoles | Systemic |
| Pyraclostrobin | 25.00% | 600 | Methoxy acrylic acid | Systemic |
Disclaimer/Publisher’s Note: The statements, opinions and data contained in all publications are solely those of the individual author(s) and contributor(s) and not of MDPI and/or the editor(s). MDPI and/or the editor(s) disclaim responsibility for any injury to people or property resulting from any ideas, methods, instructions or products referred to in the content. |
© 2023 by the authors. Licensee MDPI, Basel, Switzerland. This article is an open access article distributed under the terms and conditions of the Creative Commons Attribution (CC BY) license (https://creativecommons.org/licenses/by/4.0/).
Share and Cite
Liu, Y.; Song, C.; Ren, X.; Wu, G.; Ma, Z.; Zhao, M.; Xie, Y.; Li, Y.; Lai, Y. Screening for Fungicide Efficacy in Controlling Blackleg Disease in Wasabi (Eutrema japonicum). Plants 2023, 12, 3149. https://doi.org/10.3390/plants12173149
Liu Y, Song C, Ren X, Wu G, Ma Z, Zhao M, Xie Y, Li Y, Lai Y. Screening for Fungicide Efficacy in Controlling Blackleg Disease in Wasabi (Eutrema japonicum). Plants. 2023; 12(17):3149. https://doi.org/10.3390/plants12173149
Chicago/Turabian StyleLiu, Yanjun, Changjiang Song, Xin Ren, Guoli Wu, Zihan Ma, Mantong Zhao, Yujia Xie, Yu Li, and Yunsong Lai. 2023. "Screening for Fungicide Efficacy in Controlling Blackleg Disease in Wasabi (Eutrema japonicum)" Plants 12, no. 17: 3149. https://doi.org/10.3390/plants12173149
APA StyleLiu, Y., Song, C., Ren, X., Wu, G., Ma, Z., Zhao, M., Xie, Y., Li, Y., & Lai, Y. (2023). Screening for Fungicide Efficacy in Controlling Blackleg Disease in Wasabi (Eutrema japonicum). Plants, 12(17), 3149. https://doi.org/10.3390/plants12173149

